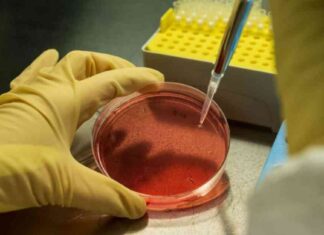
Potential of Personalized Cancer Vaccine in Treating Kidney Cancer potential-of-personalized-cancer-vaccine-in-treating-kidney-cancer

Tag: Precision medicine in oncology
Potential of Personalized Cancer Vaccine in Treating Kidney Cancer
A groundbreaking study published in Nature has unveiled promising results in the realm of cancer treatment, specifically in the context of kidney cancer. The research highlights the efficacy of personalized cancer vaccines tailored to...